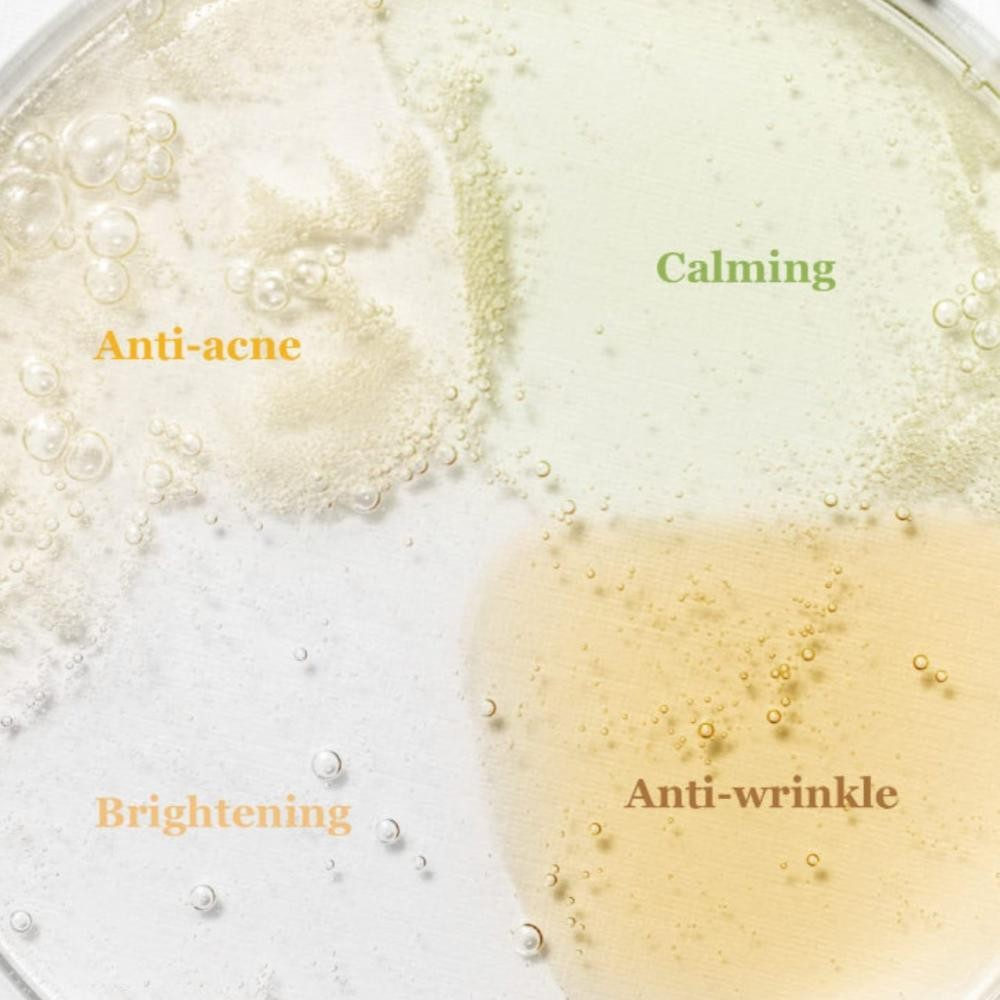

صُممت هذه المجموعة المصغرة لتمنحكِ فرصة لتجربة أربعة من أفضل سيرومات العلامة التجارية، والتي تجمع بين الحكمة التقليدية الكورية "هانبانغ" والمكونات الحديثة الفعالة. كل سيروم في هذه المجموعة يستهدف مشكلة معينة، مما يتيح لكِ اختيار ما يناسب احتياجات بشرتكِ.
محتويات المجموعة:
- Revive Serum (30 مل) - الجينسنغ و الحلزون: سيروم مصمم لمكافحة علامات تقدم السن. غني بمستخلص الجينسنغومستخلص الحلزون لتجديد البشرة، وتحسين مرونتها، وتقليل الخطوط الدقيقة.
- Glow Serum (30 مل) - البروبوليس و النياسيناميد: سيروم لتغذية البشرة ومنحها إشراقة. يحتوي على مستخلص البروبوليس والنياسيناميد لتهدئة البشرة وتقليل البقع الداكنة، مما يمنحكِ مظهرًا صحيًا ومتوهجًا.
- Calming Serum (30 مل) - الشاي الأخضر و بانثينول: سيروم لتهدئة البشرة . تركيبته الغنية بمستخلص الشاي الأخضر والبانثينول تساعد على تهدئة الاحمرار والتهيج، وتوفير ترطيب عميق.
- Repair Serum (30 مل) - الجينسنغ و الحلزون: سيروم مصمم لمكافحة علامات تقدم السن. غني بمستخلص الجينسنغومستخلص الحلزون لتجديد البشرة، وتحسين مرونتها، وتقليل الخطوط الدقيقة.
مميزات المجموعة:
- اكتشاف مثالي: تمنحكِ المجموعة فرصة لتجربة أنواع السيروم المختلفة لتحديد الأنسب لبشرتكِ قبل شراء الحجم الكامل.
- عناية متكاملة: تغطي المجموعة احتياجات متعددة للبشرة، مثل محاربة الشيخوخة، التفتيح، والتهدئة.
- مناسبة للسفر: حجم العبوات الصغير يجعلها مثالية للسفر أو للتنقل.